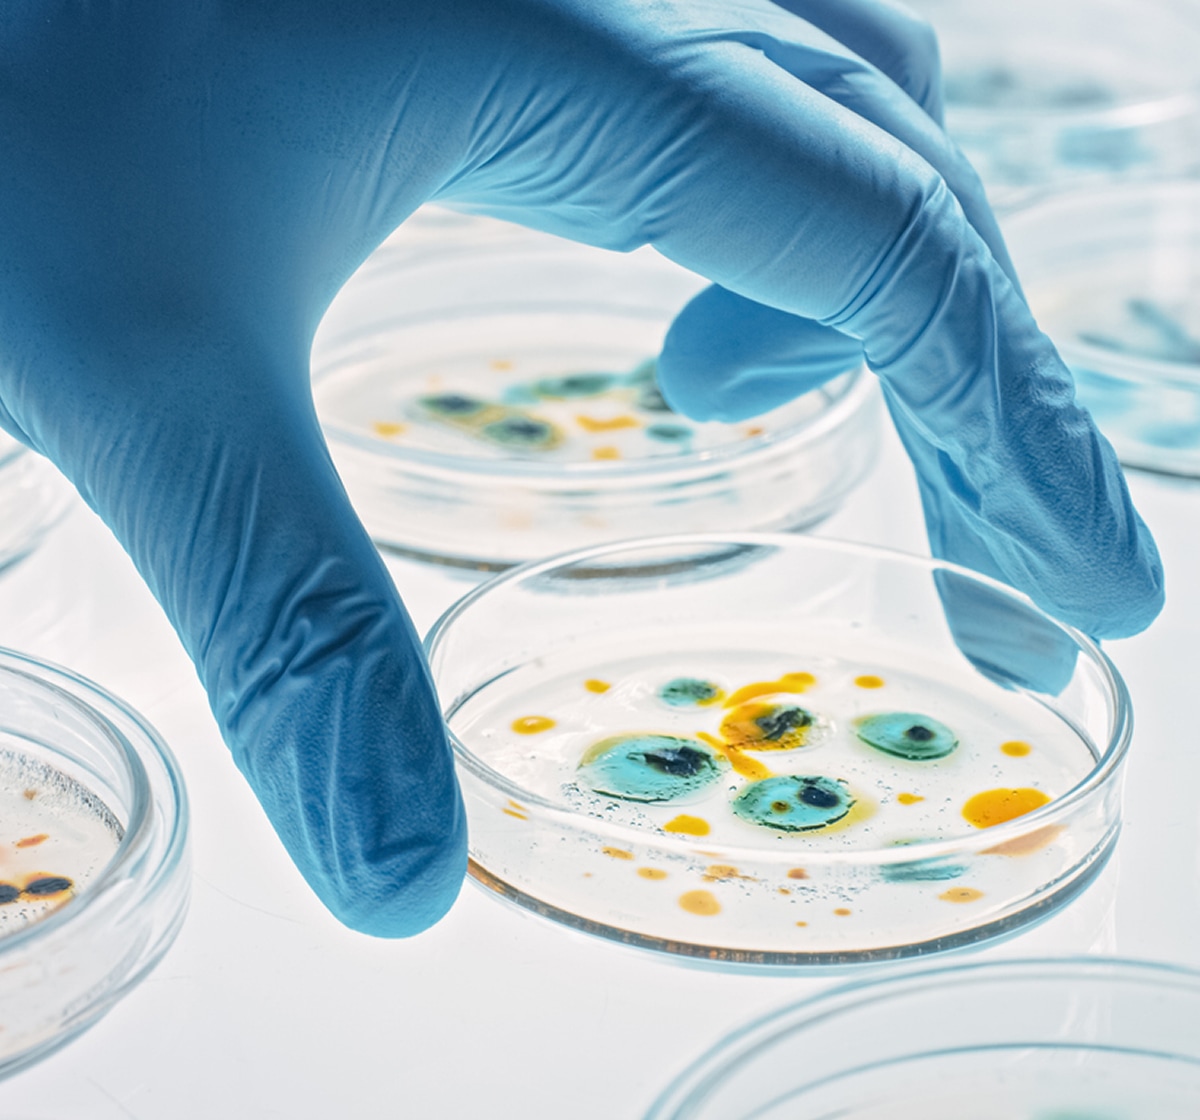

Focus Areas
Key Focus Areas
MassCPR convenes three interdisciplinary working‑group seminar series that bring together researchers, clinicians, policymakers, and public health leaders from across the U.S.
These monthly discussions draw hundreds of participants, highlight emerging challenges and frontline experiences, and showcase innovative approaches to strengthening infectious disease preparedness, fostering collaboration and knowledge sharing across disciplines.

Diagnostics, Surveillance, and Epidemiology
Explore how diagnostics, data, and epidemiological methods are advancing the detection, monitoring, and prediction of infectious diseases. This series brings together experts from academia, clinical medicine, public health, and industry to share innovations in surveillance systems, diagnostic strategies, and modeling approaches. Topics include environmental and genomic surveillance, emerging diagnostic technologies, and real-world decision-making in clinical and public health settings, with an emphasis on strengthening preparedness and response to evolving health threats.

Post-Infectious Clinical Syndromes
Examine the long-term health impacts of infectious diseases, including persistent and post-acute conditions such as Long COVID. This series brings together clinicians, researchers, and public health experts to explore underlying biological mechanisms—such as immune dysregulation, viral persistence, and recovery pathways—alongside clinical manifestations and patient experiences. Discussions also address equity, access, and the broader societal impacts of these conditions, with the goal of advancing more effective and inclusive approaches to care.

Variants and Vaccines
Track the evolving landscape of infectious diseases through the study of viral variants, immune response, and vaccine development. This series convenes experts across disciplines to share insights on virus–host interactions, immunological protection, and vaccine strategy. Discussions draw on global perspectives and a wide range of pathogens, highlighting emerging threats, zoonotic transmission, and approaches to strengthening prevention and response.
Join Our Seminar Series & Get Updates
Attend our seminar series focused on emerging technologies, long-term condition treatments, and evolving pathogens – and stay informed about upcoming events and progress.
Biospecimen Program
Access biospecimens from consortium biobanks to support clinical studies, and outbreak preparedness. Explore available collections and request samples for your research program.
Support Our Work
Help us stop infectious diseases and strengthen readiness for future outbreaks. As a non-profit, MassCPR relies on the generosity of donors to fund the research and clinical innovation that save lives.

